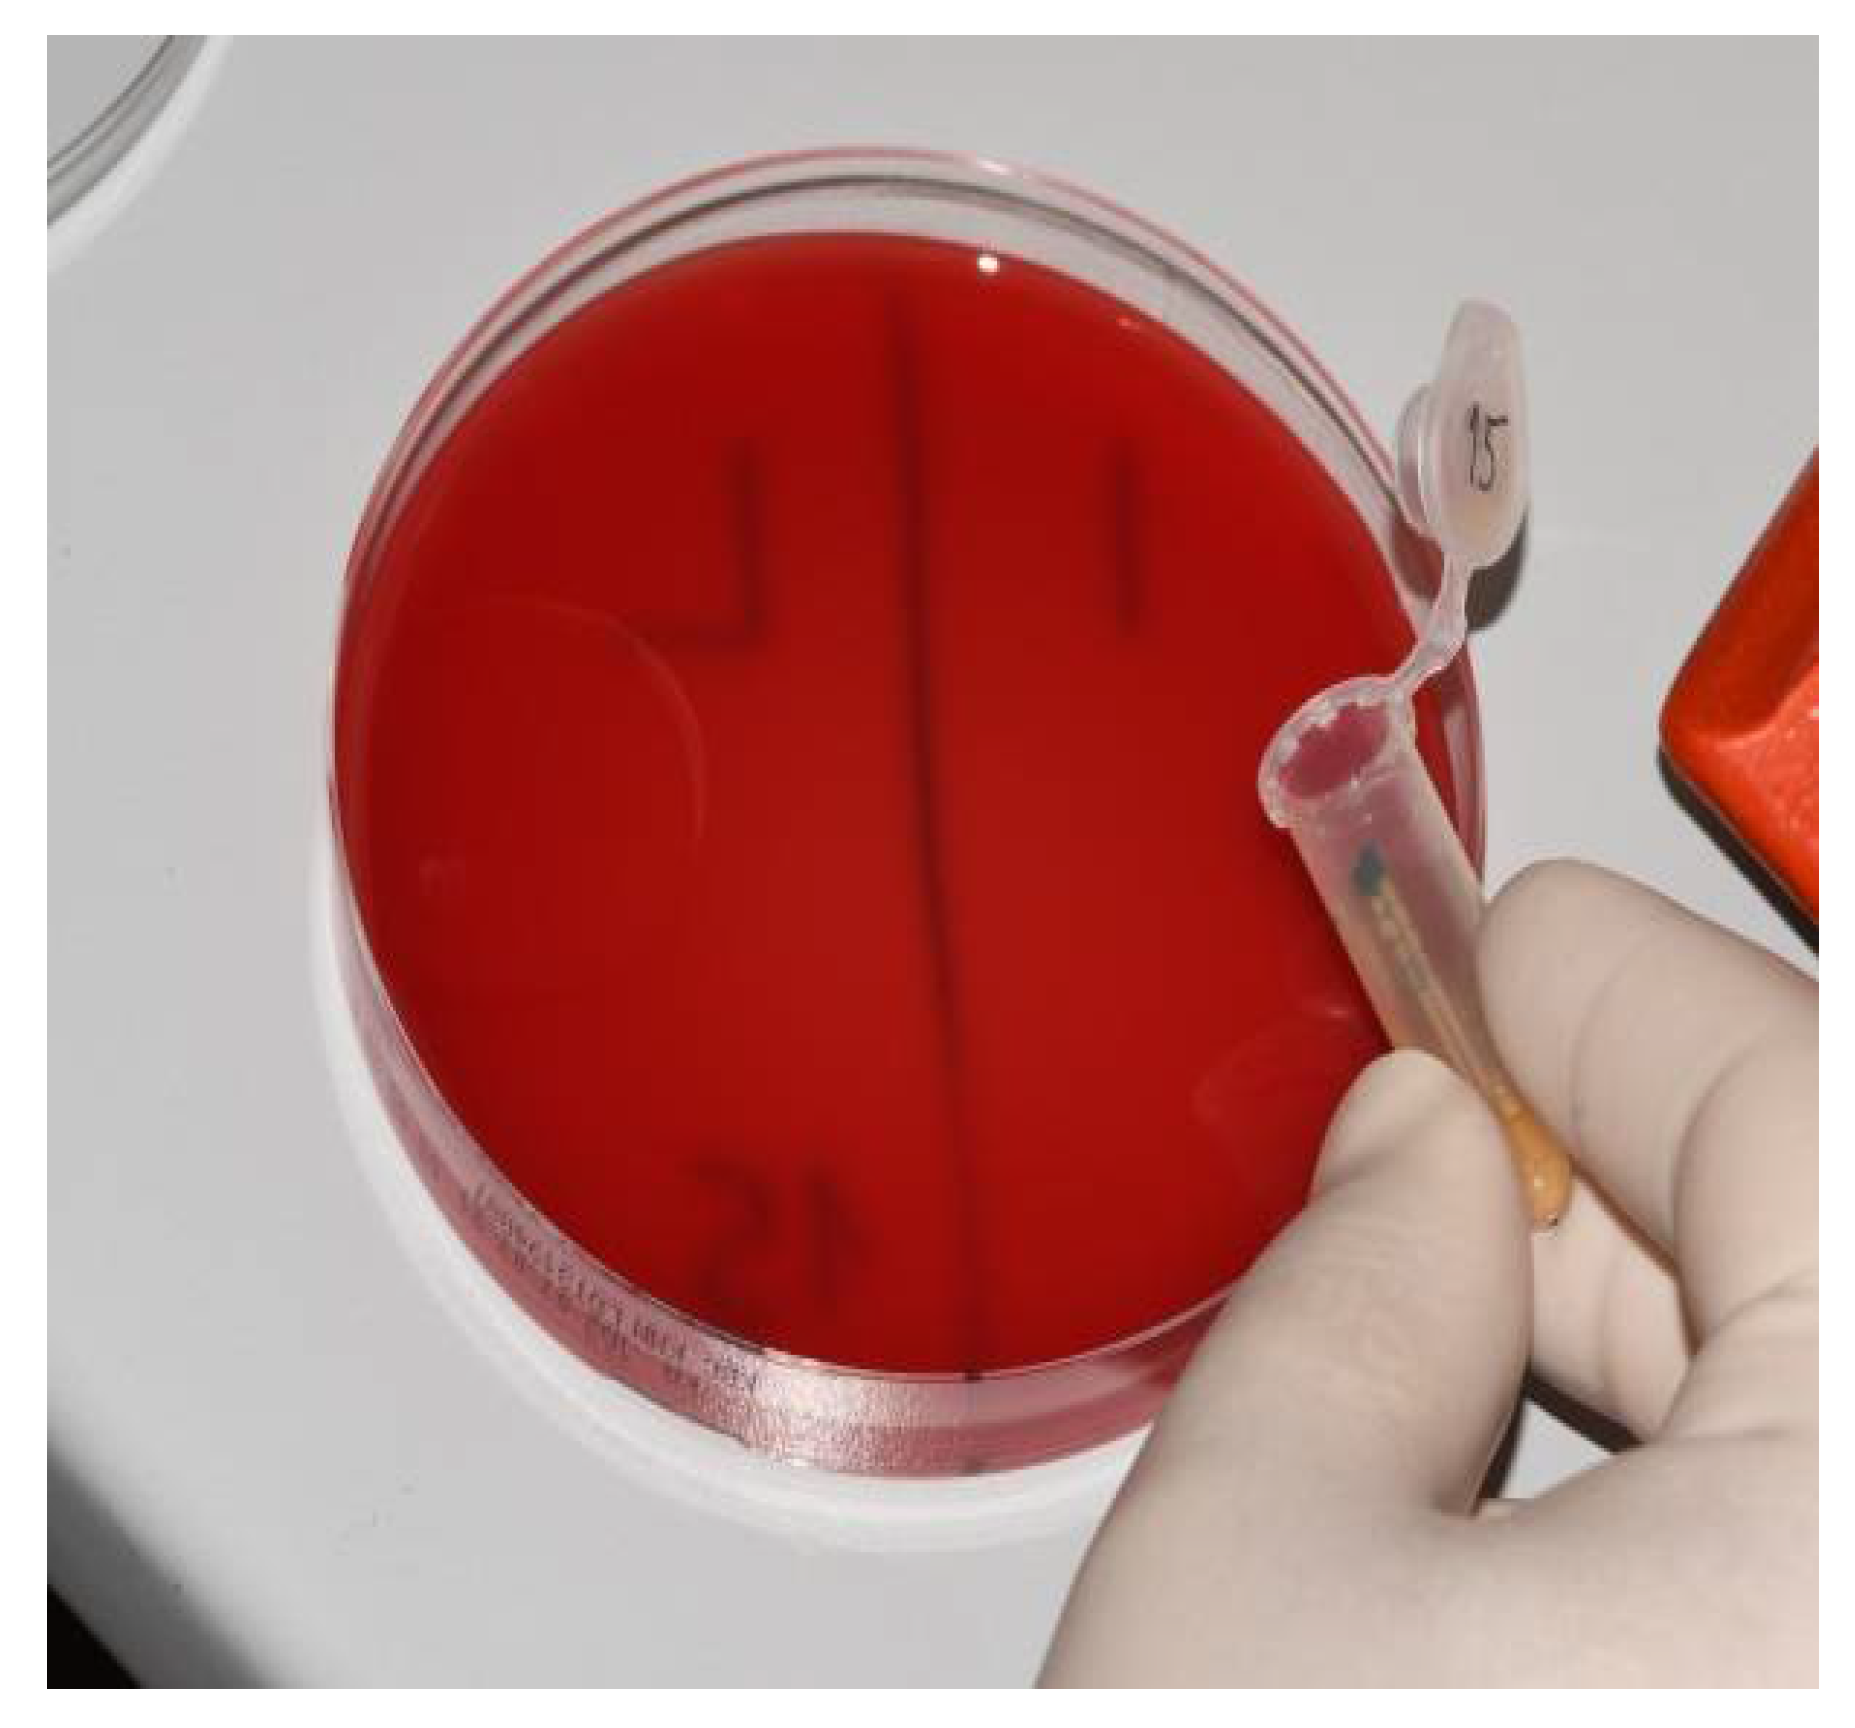
Materials 15 01597 g008

Sealing Efficacy of the Original and Third-Party Custom-Made Abutments—Microbiological In Vitro Pilot Study
Abstract
:1. Introduction
2. Materials and Methods
2.1. Study Design
2.2. Preparation of the IAC
2.3. Contamination of Implant–Abutment Interfaces
2.4. Statistical Analysis
3. Results
4. Discussion
5. Conclusions
Author Contributions
Funding
Institutional Review Board Statement
Informed Consent Statement
Data Availability Statement
Conflicts of Interest
References
- Hong, D.G.K.; Oh, J. Recent Advances in Dental Implants. Maxillofac. Plast. Reconstr. Surg. 2017, 39, 33. [Google Scholar] [CrossRef] [PubMed] [Green Version]
- Koutouzis, T. Implant-Abutment Connection as Contributing Factor to Peri-Implant Diseases. Periodontol. 2000 2019, 81, 152–166. [Google Scholar] [CrossRef] [PubMed]
- Vetromilla, B.M.; Brondani, L.P.; Pereira-Cenci, T.; Bergoli, C.D. Influence of Different Implant-Abutment Connection Designs on the Mechanical and Biological Behavior of Single-Tooth Implants in the Maxillary Esthetic Zone: A Systematic Review. J. Prosthet. Dent. 2019, 121, 398–403.e3. [Google Scholar] [CrossRef] [PubMed]
- Lauritano, D.; Moreo, G.; Lucchese, A.; Viganoni, C.; Limongelli, L.; Carinci, F. The Impact of Implant–Abutment Connection on Clinical Outcomes and Microbial Colonization: A Narrative Review. Materials (Basel) 2020, 13, 1131. [Google Scholar] [CrossRef] [Green Version]
- Sinjari, B.; D’Addazio, G.; De Tullio, I.; Traini, T.; Caputi, S. Peri-Implant Bone Resorption during Healing Abutment Placement: The Effect of a 0.20% Chlorhexidine Gel vs. Placebo—A Randomized Double Blind Controlled Human Study. Biomed. Res. Int. 2018, 2018, 5326340. [Google Scholar] [CrossRef] [Green Version]
- D’Ercole, S.; D’Addazio, G.; Di Lodovico, S.; Traini, T.; Di Giulio, M.; Sinjari, B. Porphyromonas Gingivalis Load is Balanced by 0.20% Chlorhexidine Gel. A Randomized, Double-Blind, Controlled, Microbiological and Immunohistochemical Human Study. J. Clin. Med. 2020, 9, 284. [Google Scholar] [CrossRef] [Green Version]
- Carinci, F.; Lauritano, D.; Cura, F.; Lopez, M.A.; Andreasi Bassi, M.; Confalone, L.; Pezzetti, F. Prevention of Bacterial Leakage at Implant-Abutment Connection Level: An in Vitro Study of the Efficacy of Three Different Implant Systems. J. Biol. Regul. Homeost. Agents 2016, 30, 69–73. [Google Scholar]
- Tallarico, M.; Fiorellini, J.; Nakajima, Y.; Omori, Y.; Takahisa, I.; Canullo, L. Mechanical Outcomes, Microleakage, and Marginal Accuracy at the Implant-Abutment Interface of Original versus Nonoriginal Implant Abutments: A Systematic Review of In Vitro Studies. Biomed. Res. Int. 2018, 2018, 2958982. [Google Scholar] [CrossRef] [Green Version]
- Smojver, I.; Vuletić, M.; Gerbl, D.; Budimir, A.; Sušić, M.; Gabrić, D. Evaluation of Antimicrobial Efficacy and Permeability of Various Sealing Materials at the Implant–Abutment Interface—A Pilot In Vitro Study. Materials 2021, 14, 385. [Google Scholar] [CrossRef]
- Hager & Werken. Available online: https://www.hagerwerken.de/wp-content/uploads/2018/09/GapSeal-GBA-16S-A7-Rev05-0918-kl-1.pdf (accessed on 5 December 2021).
- Ito, T.; Mori, G.; Oda, Y.; Hirano, T.; Sasaki, H.; Honma, S.; Furuya, Y.; Yajima, Y. Clinical evaluation of periodontal pathogen levels by real-time polymerase chain reaction in peri-implantitis patients. Int. J. Implant Dent. 2021, 7, 105. [Google Scholar] [CrossRef]
- Mombelli, A.; Décaillet, F. The Characteristics of Biofilms in Peri-Implant Disease. J. Clin. Periodontol. 2011, 38, 203–213. [Google Scholar] [CrossRef] [PubMed] [Green Version]
- Belibasakis, G.N.; Charalampakis, G.; Bostanci, N.; Stadlinger, B. Peri-Implant Infections of Oral Biofilm Etiology. Adv. Exp. Med. Biol. 2015, 830, 69–84. [Google Scholar]
- Albertini, M.; López-Cerero, L.; O’Sullivan, M.G.; Chereguini, C.F.; Ballesta, S.; Ríos, V.; Herrero-Climent, M.; Bullón, P. Assessment of Periodontal and Opportunistic Flora in Patients with Peri-Implantitis. Clin. Oral Implants Res. 2015, 26, 937–941. [Google Scholar] [CrossRef] [PubMed]
- Persson, G.R.; Renvert, S. Cluster of Bacteria Associated with Peri-Implantitis. Clin. Implant Dent. Relat. Res. 2014, 16, 783–793. [Google Scholar] [CrossRef]
- Smojver, I.; Vuletić, M.; Sušić, M.; Marković, L.; Pelivan, I.; Gabrić, D. The role of Candida species in peri-implant diseases. Australas. Med. J. 2020, 13, 98–105. [Google Scholar] [CrossRef]
- do Nascimento, C.; Pita, M.S.; Pedrazzi, V.; de Albuquerque, R.F., Jr.; Ribeiro, R.F. In vivo evaluation of Candida spp. adhesion on titanium or zirconia abutment surfaces. Arch. Oral Biol. 2013, 58, 853–861. [Google Scholar] [CrossRef]
- Alonso-Pérez, R.; Bartolomé, J.; Ferreiroa, A.; Salido, M.; Pradíes, G. Evaluation of the Mechanical Behavior and Marginal Accuracy of Stock and Laser-Sintered Implant Abutments. Int. J. Prosthodont. 2017, 30, 136–138. [Google Scholar] [CrossRef] [PubMed] [Green Version]
- Alonso-Pérez, R.; Bartolomé, J.F.; Ferreiroa, A.; Salido, M.P.; Pradíes, G. Original vs. Non-Original Abutments for Screw-Retained Single Implant Crowns: An in Vitro Evaluation of Internal Fit, Mechanical Behaviour and Screw Loosening. Clin. Oral Implants Res. 2018, 29, 1230–1238. [Google Scholar] [CrossRef]
- Berberi, A.; Tehini, G.; Rifai, K.; Bou Nasser Eddine, F.; Badran, B.; Akl, H. Leakage Evaluation of Original and Compatible Implant-Abutment Connections: In Vitro Study Using Rhodamine B. J. Dent. Biomech. 2014, 5, 1–7. [Google Scholar] [CrossRef]
- Duarte, A.R.C.; Rossetti, P.H.O.; Rossetti, L.M.N.; Torres, S.A.; Bonachela, W.C. In Vitro Sealing Ability of Two Materials at Five Different Implant-Abutment Surfaces. J. Periodontol. 2006, 77, 1828–1832. [Google Scholar] [CrossRef]
- Nayak, A.G.; Fernandes, A.; Kulkarni, R.; Ajantha, G.S.; Lekha, K.; Nadiger, R. Efficacy of Antibacterial Sealing Gel and O-Ring to Prevent Microleakage at the Implant Abutment Interface: An in Vitro Study. J. Oral Implantol. 2014, 40, 11–14. [Google Scholar] [CrossRef] [PubMed]
- Mishra, S.K.; Chowdhary, R.; Kumari, S. Microleakage at the Different Implant Abutment Interface: A Systematic Review. J. Clin. Diagn. Res. 2017, 11, 10–15. [Google Scholar] [CrossRef]
- Sasada, Y.; Cochran, D. Implant-Abutment Connections: A Review of Biologic Consequences and Peri-implantitis Implications. Int. J. Oral Maxillofac. Implants 2017, 32, 1296–1307. [Google Scholar] [CrossRef] [PubMed] [Green Version]
- Biscoping, S.; Ruttmann, E.; Rehmann, P.; Wöstmann, B. Do Sealing Materials Influence Superstructure Attachment in Implants? Int. J. Prosthodont. 2018, 31, 163–165. [Google Scholar] [CrossRef] [Green Version]
- Seloto, C.; Strazzi-Sahyon, H.; dos Santos, P.; Assunção, W. Effectiveness of Sealing Gel on Vertical Misfit at the Implant-Abutment Interface and Preload Maintenance of Screw-Retained Implant-Supported Prostheses. Int. J. Oral Maxillofac. Implants 2020, 35, 479–484. [Google Scholar] [CrossRef] [PubMed]
- Yu, P.; Li, Z.; Tan, X.; Yu, H. Effect of Sealing Gel on the Microleakage Resistance and Mechanical Behavior during Dynamic Loading of 3 Implant Systems. J. Prosthet. Dent. 2020, 1–10. [Google Scholar] [CrossRef]
- de Sousa, C.A.; Conforte, J.J.; Caiaffa, K.S.; Duque, C.; Assunção, W.G. Sealing Agent Reduces Formation of Single and Dual-Species Biofilms of Candida albicans and Enterococcus faecalis on Screw Joints at the Abutment/Implant Interface. PLoS ONE 2019, 14, e0223148. [Google Scholar]
- Quirynen, M.; van Steenberghe, D. Bacterial Colonization of the Internal Part of Two-stage Implants. An in Vivo Study. Clin. Oral Implants Res. 1993, 4, 158–161. [Google Scholar] [CrossRef] [PubMed]
- Steinebrunner, L.; Wolfart, S.; Bössmann, K.; Kern, M. In Vitro Evaluation of Bacterial Leakage along the Implant-Abutment Interface of Different Implant Systems. Int. J. Oral Maxillofac. Implants 2005, 20, 875–881. [Google Scholar]
- Ceruso, F. Implant-Abutment Connections on Single Crowns: A Systematic Review. Oral Implantol. 2017, 10, 349–353. [Google Scholar] [CrossRef] [PubMed]

| Microbe | Original Abutments [%] | Third-Party Custom-Made Abutments [%] | Original Abutments with GapSeal [%] | Third-Party Custom-Made Abutments with GapSeal [%] |
|---|---|---|---|---|
| Staphylococcus aureus | 80.00 (8/10) | 100.00 (10/10) | 50.00 (5/10) | 70.00 (7/10) |
| Candida albicans | 60.00 (6/10) | 80.00 (8/10) | 20.00 (2/10) | 30.00 (3/10) |
| Microbe | Original Abutments [%] | Third-Party Custom-Made Abutments [%] | Original Abutments with GapSeal [%] | Third-Party Custom-Made Abutments with GapSeal [%] |
|---|---|---|---|---|
| Staphylococcus aureus | 90.00 (9/10) | 100.00 (10/10) | 60.00 (6/10) | 60.00 (6/10) |
| Candida albicans | 60.00 (6/10) | 80.00 (8/10) | 20.00 (2/10) | 30.00 (3/10) |
| Implant | Zimmer | GC | ||
|---|---|---|---|---|
| Fisher Exact Test (p-Values) | Staphylococcus aureus | Candida albicans | Staphylococcus aureus | Candida albicans |
| Original prosthodontic abutment | H0 accepted (0.4737) | H0 accepted (0.6285) | H0 accepted (0.5000) | H0 accepted (1.0000) |
| Third-party custom-made prosthodontic abutment | H0 accepted (0.6499) | H0 accepted (1.0000) | H0 accepted (0.6285) | H0 accepted (1.0000) |
| Implant | Zimmer | GC | ||
|---|---|---|---|---|
| Fisher Exact Test (p-Values) | Staphylococcus aureus | Candida albicans | Staphylococcus aureus | Candida albicans |
| Without sealing material | 0.3498 | 0.1698 | 0.3034 | 0.1698 |
| With sealing material | 0.2105 | 0.0698 | 0.0867 | 0.0698 |
| Staphylococcus aureus | Candida albicans | |
|---|---|---|
| Zimmer | CFU/mL mean +/− SD (median) | CFU/mL mean +/− SD (median) |
| Negative control original abut. | 11.2 +/− 7.9 (11) | 1.3 +/− 1.34 (1,5) |
| Negative control third-party abut. | 76 +/− 24.59 (80) | 6.2 +/− 3.82 (6) |
| GapSeal original abut. | 5.8 +/− 6.89 (4) | 0.3 +/− 0.67 (0) |
| GapSeal third-party abut. | 32 +/− 25.3 (40) | 2.8 +/− 4.54 (0) |
| GC Aadva | CFU/mL mean +/− SD (median) | CFU/mL mean +/− SD (median) |
| Negative control original abut. | 15.2 +/− 6.68 (18) | 1.5 +/− 1.58 (1.5) |
| Negative control third-party abut. | 66 +/− 25.03 (60) | 8.6 +/− 5.08 (10) |
| GapSeal original abut. | 8 +/− 7.89 (10) | 0.3 +/− 0.67 (0) |
| GapSeal third-party abut. | 46 +/− 44.27 (50) | 2.2 +/− 3.82 (0) |
Publisher’s Note: MDPI stays neutral with regard to jurisdictional claims in published maps and institutional affiliations. |
© 2022 by the authors. Licensee MDPI, Basel, Switzerland. This article is an open access article distributed under the terms and conditions of the Creative Commons Attribution (CC BY) license (https://creativecommons.org/licenses/by/4.0/).
Share and Cite
Smojver, I.; Bjelica, R.; Ćatić, A.; Budimir, A.; Vuletić, M.; Gabrić, D. Sealing Efficacy of the Original and Third-Party Custom-Made Abutments—Microbiological In Vitro Pilot Study. Materials 2022, 15, 1597. https://doi.org/10.3390/ma15041597
Smojver I, Bjelica R, Ćatić A, Budimir A, Vuletić M, Gabrić D. Sealing Efficacy of the Original and Third-Party Custom-Made Abutments—Microbiological In Vitro Pilot Study. Materials. 2022; 15(4):1597. https://doi.org/10.3390/ma15041597
Chicago/Turabian StyleSmojver, Igor, Roko Bjelica, Amir Ćatić, Ana Budimir, Marko Vuletić, and Dragana Gabrić. 2022. "Sealing Efficacy of the Original and Third-Party Custom-Made Abutments—Microbiological In Vitro Pilot Study" Materials 15, no. 4: 1597. https://doi.org/10.3390/ma15041597







